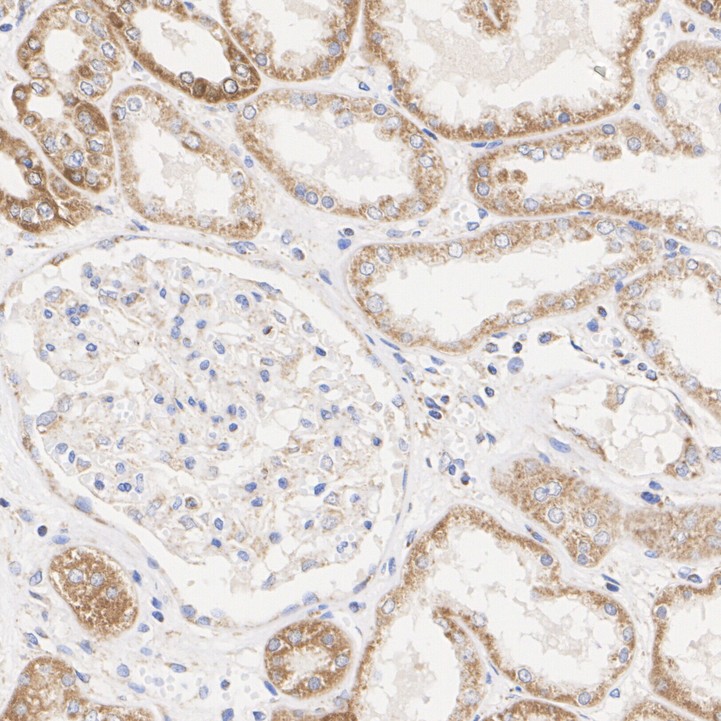

TOMM20 Recombinant Rabbit Monoclonal Antibody [ST04-72] - BSA and Azide free

Rmb: 5600 特惠
产品规格
Catalog# HA750166
TOMM20 Recombinant Rabbit Monoclonal Antibody [ST04-72] - BSA and Azide free
-
WB
-
IHC-P
-
IF-Tissue
-
IF-Cell
-
FC
-
IP
-
IHC-Fr
-
Human
-
Mouse
-
Rat
-
ET1609-25
含抗保成分
-
unconjugated
Safety datasheet
概述
产品名称
TOMM20 Recombinant Rabbit Monoclonal Antibody [ST04-72] - BSA and Azide free
抗体类型
Recombinant Rabbit monoclonal Antibody
免疫原
Recombinant protein within Human TOMM20 aa 1-145 / 145.
种属反应性
Human, Mouse, Rat
验证应用
WB, IHC-P, IF-Tissue, IF-Cell, FC, IP, IHC-Fr
分子量
Predicted band size: 16 kDa
阳性对照
HeLa cell lysate, Saos-2 cell lysate, HepG2 cell lysate, A549 cell lysate, NIH/3T3 cell lysate, C2C12 cell lysate, C6 cell lysate, PC-12 cell lysate, Mouse brain tissue lysate, Rat brain tissue lysate, MCF7 cell lysate, F9 cell lysate, Rat lung tissue lysate, HepG2, NIH/3T3, HeLa, human kidney tissue, rat kidney tissue, mouse kidney tissue, human liver tissue, rat large intestine tissue.
偶联
unconjugated
克隆号
ST04-72
产品特性
形态
Liquid
浓度
存放说明
Store at +4℃ after thawing. Aliquot store at -20℃ or -80℃. Avoid repeated freeze / thaw cycles.
存储缓冲液
1*PBS (pH7.4).
亚型
IgG
纯化方式
Protein A affinity purified.
应用稀释度
-
WB
-
1:5,000-1:20,000
-
IHC-P
-
1:500-1:1,000
-
IHC-Fr
-
1:500
-
IF-Tissue
-
1:500
-
IF-Cell
-
1:1,000
-
FC
-
1:1,000
-
IP
-
Use at an assay dependent concentration.
靶点
功能
Mitochondrial import receptor subunit TOM20 homolog is a protein that in humans is encoded by the TOMM20 gene. TOM20 is one of the receptor systems of the translocase of the outer membrane (TOM) complex in the outer mitochondrial membrane. In mitochondrial protein import, TOM20 is closely associated with the pore-forming TOM40 complex and acts by recognizing and binding the N-terminal MTSs (matrix-targeting sequences), which form an amphipathic alpha helix and aid passage of the target proteins into the mitochondrial matrix.
背景文献
1. Micaily I et al. TOMM20 as a Potential Prognostic Biomarker in Chordoma: Results From a High-Volume, Single-Center Study. Am J Clin Pathol. 2023 May
2. Yin L et al. AR antagonists develop drug resistance through TOMM20 autophagic degradation-promoted transformation to neuroendocrine prostate cancer. J Exp Clin Cancer Res. 2023 Aug
序列相似性
Belongs to the Tom20 family.
翻译后修饰
Ubiquitinated by PRKN during mitophagy, leading to its degradation and enhancement of mitophagy. Deubiquitinated by USP30.
亚细胞定位
Mitochondrion outer membrane.
别名
KIAA0016 antibody
MAS20 antibody
MGC117367 antibody
Mitochondrial 20 kDa outer membrane protein antibody
Mitochondrial import receptor subunit TOM20 homolog antibody
MOM19 antibody
Outer mitochondrial membrane receptor Tom20 antibody
TOM20 antibody
TOM20_HUMAN antibody
TOMM20 antibody
展开KIAA0016 antibody
MAS20 antibody
MGC117367 antibody
Mitochondrial 20 kDa outer membrane protein antibody
Mitochondrial import receptor subunit TOM20 homolog antibody
MOM19 antibody
Outer mitochondrial membrane receptor Tom20 antibody
TOM20 antibody
TOM20_HUMAN antibody
TOMM20 antibody
Translocase of outer mitochondrial membrane 20 homolog (yeast) antibody
Translocase of outer mitochondrial membrane 20 homolog type II antibody
折叠图片
-

☑ Relative expression (RE)
Western blot analysis of TOMM20 on different lysates with Rabbit anti-TOMM20 antibody (HA750166) at 1/5,000 dilution and competitor's antibody at 1/1,000 dilution.
Lane 1: HeLa cell lysate (15 µg/Lane)
Lane 2: Saos-2 cell lysate (low expression) (15 µg/Lane)
Lane 3: HepG2 cell lysate (15 µg/Lane)
Lane 4: A549 cell lysate (15 µg/Lane)
Lane 5: NIH/3T3 cell lysate (15 µg/Lane)
Lane 6: C2C12 cell lysate (15 µg/Lane)
Lane 7: C6 cell lysate (15 µg/Lane)
Lane 8: PC-12 cell lysate (15 µg/Lane)
Lane 9: Mouse brain tissue lysate (30 µg/Lane)
Lane 10: Rat brain tissue lysate (30 µg/Lane)
Predicted band size: 16 kDa
Observed band size: 16 kDa
Exposure time: 3 minutes; ECL: K1801;
4-20% SDS-PAGE gel.
Proteins were transferred to a PVDF membrane and blocked with 5% NFDM/TBST for 1 hour at room temperature. The primary antibody (HA750166) at 1/5,000 dilution and competitor's antibody at 1/1,000 dilution were used in 5% NFDM/TBST at 4℃ overnight. Goat Anti-Rabbit IgG - HRP Secondary Antibody (HA1001) at 1/50,000 dilution was used for 1 hour at room temperature. -

☑ Knockdown (KD)
Western blot analysis of TOMM20 on different lysates with Rabbit anti-TOMM20 antibody (HA750166) at 1/5,000 dilution.
Lane 1: HeLa-si NT cell lysate (10 µg/Lane)
Lane 2: HeLa-si TOMM20 cell lysate (10 µg/Lane)
Predicted band size: 16 kDa
Observed band size: 16 kDa
Exposure time: 21 seconds; ECL: K1801;
4-20% SDS-PAGE gel.
Proteins were transferred to a PVDF membrane and blocked with 5% NFDM/TBST for 1 hour at room temperature. The primary antibody (HA750166) at 1/5,000 dilution was used in 5% NFDM/TBST at 4℃ overnight. Goat Anti-Rabbit IgG - HRP Secondary Antibody (HA1001) at 1/50,000 dilution was used for 1 hour at room temperature. -

☑ Relative expression (RE)
Western blot analysis of TOMM20 on different lysates with Rabbit anti-TOMM20 antibody (HA750166) at 1/5,000 dilution.
Lane 1: HeLa cell lysate (10 µg/Lane)
Lane 2: Saos-2 cell lysate (low expression) (10 µg/Lane)
Lane 3: HepG2 cell lysate (10 µg/Lane)
Lane 4: A549 cell lysate (10 µg/Lane)
Lane 5: MCF7 cell lysate (10 µg/Lane)
Lane 6: NIH/3T3 cell lysate (10 µg/Lane)
Lane 7: F9 cell lysate (10 µg/Lane)
Lane 8: PC-12 cell lysate (10 µg/Lane)
Lane 9: Mouse brain tissue lysate (20 µg/Lane)
Lane 10: Rat brain tissue lysate (20 µg/Lane)
Lane 11: Rat lung tissue lysate (20 µg/Lane)
Predicted band size: 16 kDa
Observed band size: 16 kDa
Exposure time: 1 minute 22 seconds; ECL: K1801;
4-20% SDS-PAGE gel.
Proteins were transferred to a PVDF membrane and blocked with 5% NFDM/TBST for 1 hour at room temperature. The primary antibody (HA750166) at 1/5,000 dilution was used in 5% NFDM/TBST at room temperature for 2 hours. Goat Anti-Rabbit IgG - HRP Secondary Antibody (HA1001) at 1/100,000 dilution was used for 1 hour at room temperature. -

Application: IF-cell
Species: Human
Cell Sample: HeLa cell
Antibody concentration: 1: 1,000
Date by conrtesy of: Mr. Wenxiang Huang
School of Basic Medical Sicences, Zhejiang University -

Application: IF-cell
Species: Human
Cell Sample: AC16 cell
Antibody concentration: 1: 200
Date by conrtesy of: Mr. Zhiyi Yang
School of Basic Medical Sicences, Zhejiang University -

☑ Relative expression (RE)
Immunocytochemistry analysis of HepG2 (high expression) and Saos-2 (low expression) labeling TOMM20 with Rabbit anti-TOMM20 antibody (HA750166) at 1/1,000 dilution and competitor's antibody at 1/400 dilution.
Cells were fixed in 4% paraformaldehyde for 20 minutes at room temperature, permeabilized with 0.1% Triton X-100 in PBS for 5 minutes at room temperature, then blocked with 1% BSA in 10% negative goat serum for 1 hour at room temperature. Cells were then incubated with Rabbit anti-TOMM20 antibody (HA750166) at 1/1,000 dilution and competitor's antibody at 1/400 dilution in 1% BSA in PBST overnight at 4 ℃. Goat Anti-Rabbit IgG H&L (iFluor™ 488, HA1121) was used as the secondary antibody at 1/1,000 dilution. PBS instead of the primary antibody was used as the secondary antibody only control. Nuclear DNA was labelled in blue with DAPI.
Beta tubulin (M1305-2, red) was stained at 1/100 dilution overnight at +4℃. Goat Anti-Mouse IgG H&L (iFluor™ 594, HA1126) was used as the secondary antibody at 1/1,000 dilution. -

Immunocytochemistry analysis of NIH/3T3 cells labeling TOMM20 with Rabbit anti-TOMM20 antibody (HA750166) at 1/1,000 dilution and competitor's antibody at 1/400 dilution.
Cells were fixed in 4% paraformaldehyde for 20 minutes at room temperature, permeabilized with 0.1% Triton X-100 in PBS for 5 minutes at room temperature, then blocked with 1% BSA in 10% negative goat serum for 1 hour at room temperature. Cells were then incubated with Rabbit anti-TOMM20 antibody (HA750166) at 1/1,000 dilution and competitor's antibody at 1/400 dilution in 1% BSA in PBST overnight at 4 ℃. Goat Anti-Rabbit IgG H&L (iFluor™ 488, HA1121) was used as the secondary antibody at 1/1,000 dilution. PBS instead of the primary antibody was used as the secondary antibody only control. Nuclear DNA was labelled in blue with DAPI.
Beta tubulin (M1305-2, red) was stained at 1/100 dilution overnight at +4℃. Goat Anti-Mouse IgG H&L (iFluor™ 594, HA1126) was used as the secondary antibody at 1/1,000 dilution. -

Immunocytochemistry analysis of HeLa cells labeling TOMM20 with Rabbit anti-TOMM20 antibody (HA750166) at 1/1,000 dilution.
Cells were fixed in 4% paraformaldehyde for 15 minutes at room temperature, permeabilized with 0.1% Triton X-100 in PBS for 15 minutes at room temperature, then blocked with 1% BSA in 10% negative goat serum for 1 hour at room temperature. Cells were then incubated with Rabbit anti-TOMM20 antibody (HA750166) at 1/1,000 dilution in 1% BSA in PBST overnight at 4 ℃. Goat Anti-Rabbit IgG H&L (iFluor™ 488, HA1121) was used as the secondary antibody at 1/1,000 dilution. PBS instead of the primary antibody was used as the secondary antibody only control. Counterstained with Mitotracker. Nuclear DNA was labelled in blue with DAPI. -
Immunohistochemical analysis of paraffin-embedded human kidney tissue with Rabbit anti-TOMM20 antibody (HA750166) at 1/500 dilution.
The section was pre-treated using heat mediated antigen retrieval with Tris-EDTA buffer (pH 9.0) for 20 minutes. The tissues were blocked in 1% BSA for 20 minutes at room temperature, washed with ddH2O and PBS, and then probed with the primary antibody (HA750166) at 1/500 dilution for 1 hour at room temperature. The detection was performed using an HRP conjugated compact polymer system. DAB was used as the chromogen. Tissues were counterstained with hematoxylin and mounted with DPX. -

Immunohistochemical analysis of paraffin-embedded rat kidney tissue with Rabbit anti-TOMM20 antibody (HA750166) at 1/500 dilution.
The section was pre-treated using heat mediated antigen retrieval with Tris-EDTA buffer (pH 9.0) for 20 minutes. The tissues were blocked in 1% BSA for 20 minutes at room temperature, washed with ddH2O and PBS, and then probed with the primary antibody (HA750166) at 1/500 dilution for 1 hour at room temperature. The detection was performed using an HRP conjugated compact polymer system. DAB was used as the chromogen. Tissues were counterstained with hematoxylin and mounted with DPX. -

Immunohistochemical analysis of paraffin-embedded mouse kidney tissue with Rabbit anti-TOMM20 antibody (HA750166) at 1/500 dilution.
The section was pre-treated using heat mediated antigen retrieval with Tris-EDTA buffer (pH 9.0) for 20 minutes. The tissues were blocked in 1% BSA for 20 minutes at room temperature, washed with ddH2O and PBS, and then probed with the primary antibody (HA750166) at 1/500 dilution for 1 hour at room temperature. The detection was performed using an HRP conjugated compact polymer system. DAB was used as the chromogen. Tissues were counterstained with hematoxylin and mounted with DPX. -

Immunohistochemical analysis of paraffin-embedded human liver tissue with Rabbit anti-TOMM20 antibody (HA750166) at 1/800 dilution.
The section was pre-treated using heat mediated antigen retrieval with Tris-EDTA buffer (pH 9.0) for 20 minutes. The tissues were blocked in 1% BSA for 20 minutes at room temperature, washed with ddH2O and PBS, and then probed with the primary antibody (HA750166) at 1/800 dilution for 1 hour at room temperature. The detection was performed using an HRP conjugated compact polymer system. DAB was used as the chromogen. Tissues were counterstained with hematoxylin and mounted with DPX. -

Immunohistochemical analysis of paraffin-embedded rat large intestine tissue with Rabbit anti-TOMM20 antibody (HA750166) at 1/800 dilution.
The section was pre-treated using heat mediated antigen retrieval with Tris-EDTA buffer (pH 9.0) for 20 minutes. The tissues were blocked in 1% BSA for 20 minutes at room temperature, washed with ddH2O and PBS, and then probed with the primary antibody (HA750166) at 1/800 dilution for 1 hour at room temperature. The detection was performed using an HRP conjugated compact polymer system. DAB was used as the chromogen. Tissues were counterstained with hematoxylin and mounted with DPX. -

Application: IHC-Fr
Species: Mouse
Site: Kidney
Sample: Frozen section
Antibody concentration: 1/500
Antigen retrieval: Not required -

Application: IHC-Fr
Species: Rat
Site: Kidney
Sample: Frozen section
Antibody concentration: 1/500
Antigen retrieval: Not required -

TOMM20 was immunoprecipitated in 0.2mg HeLa cell lysate with HA750166 at 2 µg/10 µl beads. Western blot was performed from the immunoprecipitate using HA750166 at 1/1,000 dilution. Anti-Rabbit IgG for IP Nano-secondary antibody (NBI01H) at 1/5,000 dilution was used for 1 hour at room temperature.
Lane 1: HeLa cell lysate (input)
Lane 2: Rabbit IgG instead of HA750166 in HeLa cell lysate
Lane 3: HA750166 IP in HeLa cell lysate
Blocking/Dilution buffer: 5% NFDM/TBST
Exposure time: 1 minute 2 seconds -

Flow cytometric analysis of HeLa cells labeling TOMM20.
Cells were fixed and permeabilized. Then stained with the primary antibody (HA750166, 1μg/mL) (red) compared with Rabbit IgG Isotype Control (green). After incubation of the primary antibody at +4℃ for an hour, the cells were stained with a iFluor™ 488 conjugate-Goat anti-Rabbit IgG Secondary antibody (HA1121) at 1/1,000 dilution for 30 minutes at +4℃. Unlabelled sample was used as a control (cells without incubation with primary antibody; black). -

Application: Immunofluorescence (IF-tissue)
Species: Mouse
Tissue: kidney
Sample: Paraffin-embedded section
Antigen retrieval: Heat-mediated, Tris-EDTA buffer (pH 9.0), 20 minutes at 95℃.
Wash buffer: 1× PBS
Endogenous peroxidase blocking: 3% H₂O₂, 10 minutes.
Blocking: 1% BSA + 10% normal goat serum, 10 minutes at room temperature.
Primary antibody: HA750166, 1/500, overnight at 4℃.
Secondary antibody: Goat Anti-Rabbit IgG (iFluor™ 488, HA1121), 1.5 hours at room temperature. -

Application: Immunofluorescence (IF-tissue)
Species: Rat
Tissue: brain
Sample: Paraffin-embedded section
Antigen retrieval: Heat-mediated, Tris-EDTA buffer (pH 9.0), 20 minutes at 95℃.
Wash buffer: 1× PBS
Endogenous peroxidase blocking: 3% H₂O₂, 10 minutes.
Blocking: 1% BSA + 10% normal goat serum, 10 minutes at room temperature.
Primary antibody: HA750166, 1/500, overnight at 4℃.
Secondary antibody: Goat Anti-Rabbit IgG (iFluor™ 488, HA1121), 1.5 hours at room temperature.
请注意: All products are "FOR RESEARCH USE ONLY AND ARE NOT INTENDED FOR DIAGNOSTIC OR THERAPEUTIC USE"


 浙公网安备 33019202000643号
浙公网安备 33019202000643号